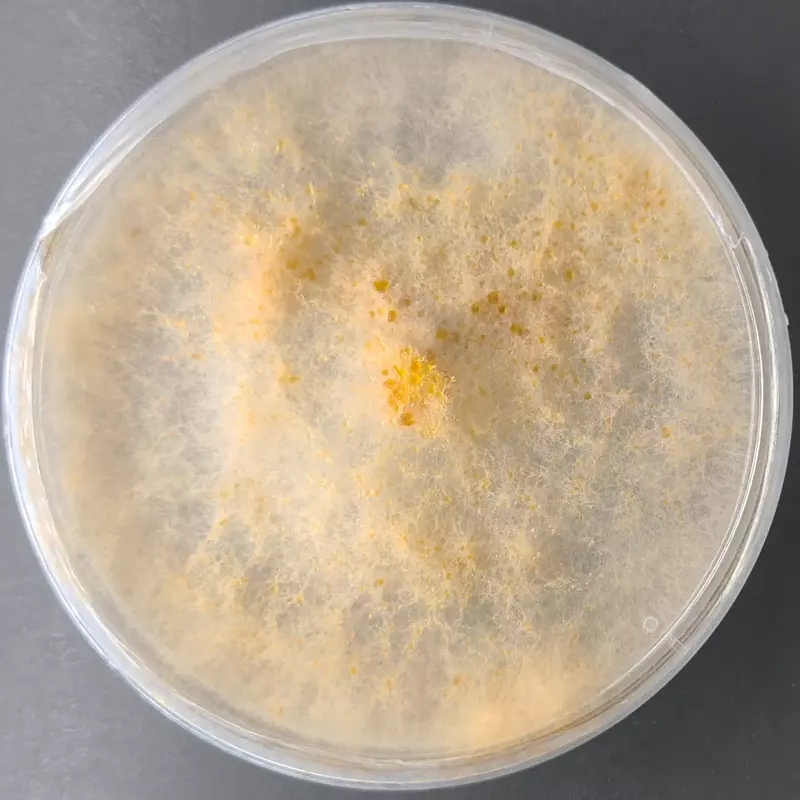

Volvariella volvacea (Paddy Straw Mushroom) – Pure Culture Plate
The Volvariella volvacea (Paddy Straw Mushroom) – Pure Culture Plate offers a verified, contamination-free strain developed for tropical and subtropical cultivation. Widely grown across Asia, this species is appreciated for its delicate flavor, nutritional value, and fast fruiting cycle.
This culture ensures vigorous mycelial growth and high biological efficiency on a variety of substrates including paddy straw, cotton waste, and composted materials. Perfect for commercial growers, training institutes, and research laboratories focusing on tropical mushroom production.
Features:
Authentic Volvariella volvacea (Paddy Straw Mushroom) strain
Fast-growing, high-yield tropical mushroom
Ideal for warm and humid climates
Nutritious, protein-rich, and gourmet-quality fruit bodies
100% pure and contamination-free culture

 |
|  |
| 
